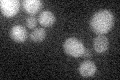
YOL064C
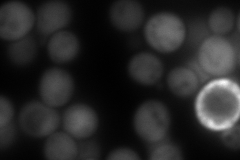
YOL064C
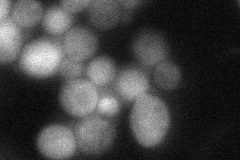
YOL064C
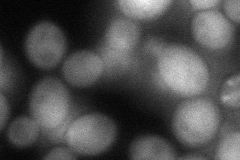
YOL064C
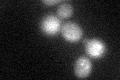
YOL064C

View description
Bisphosphate-3'-nucleotidase, involved in salt tolerance and methionine biogenesis; dephosphorylates 3'-phosphoadenosine-5'-phosphate and 3'-phosphoadenosine-5'-phosphosulfate, intermediates of the sulfate assimilation pathway
Localization:
Intensity:
Fold change:
Significance:
-
C’ GFP library in SD
below threshold15.5 -
N' NOP1pr-GFP in SD

cytosol159.128 -
N' TEF2pr-mCherry in SD
cytosol272.179 -
N' NATIVEpr-GFP in SD
cytosol44.2705 -
N' TEF2pr-VC and Cyto-VN in SD
cytosol69.9662 -
C’ GFP library in SD+DTT
cytosol18.661.2No -
C’ GFP library in SD+H2O2

cytosol19.521.25No -
C’ GFP library in Starvation Media

cytosol21.181.36No -
C’ GFP library on the background of Pup2-DaMP

below threshold -
C’ GFP library on the background of CCT mutant

below threshold15.90781.0259No
